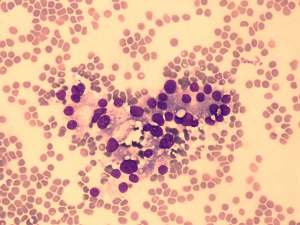

Graves' disease - case 1191 |
|
Clinical data: A 51-year-old woman was referred for an evaluation of typical signs of hyperthyroidism lasting for 5 weeks. Four months before the present examination, the patient was euthyroid with a TSH 0.71 mIU/L.
Palpation: The right lobe was enlarged and ha a not firm nodule. The left lobe was not palpable.
Laboratory tests: TSH undetectable, FT4 43.8 pM/L. TSAb-assay 8.2 U/l (normal value under 1.5).
Ultrasonography: The thyroid was moderately hypoechogenic and showed increased vascularity. There was an echonormal nodule in the right lobe with combined perinodular and intranodular vascular pattern.
Aspiration cytology from the nodule resulted in benign lesion corresponding to hyperthyroidism.
Scintigraphy indicated an autonomously functioning nodule.
Final diagnosis: Marine-Lenhart syndrome.
The patient was treated with thyrostatic drugs. After the restoration of FT4-level, surgery was performed.
Histopathology disclosed diffuse goiter corresponding to Graves' disease while a normofollicular adenoma in the right thyroid.
Comments.
-
The sudden development of a hyperthyroidism would be an unusual phenomenon in the case of a toxic nodule except for excess iodine ingestion and in the case of a coexistent Graves' disease.
-
Marine-Lenhart syndrome refers to a variant of Graves' disease where there are coexistent autonomous thyroid nodules.